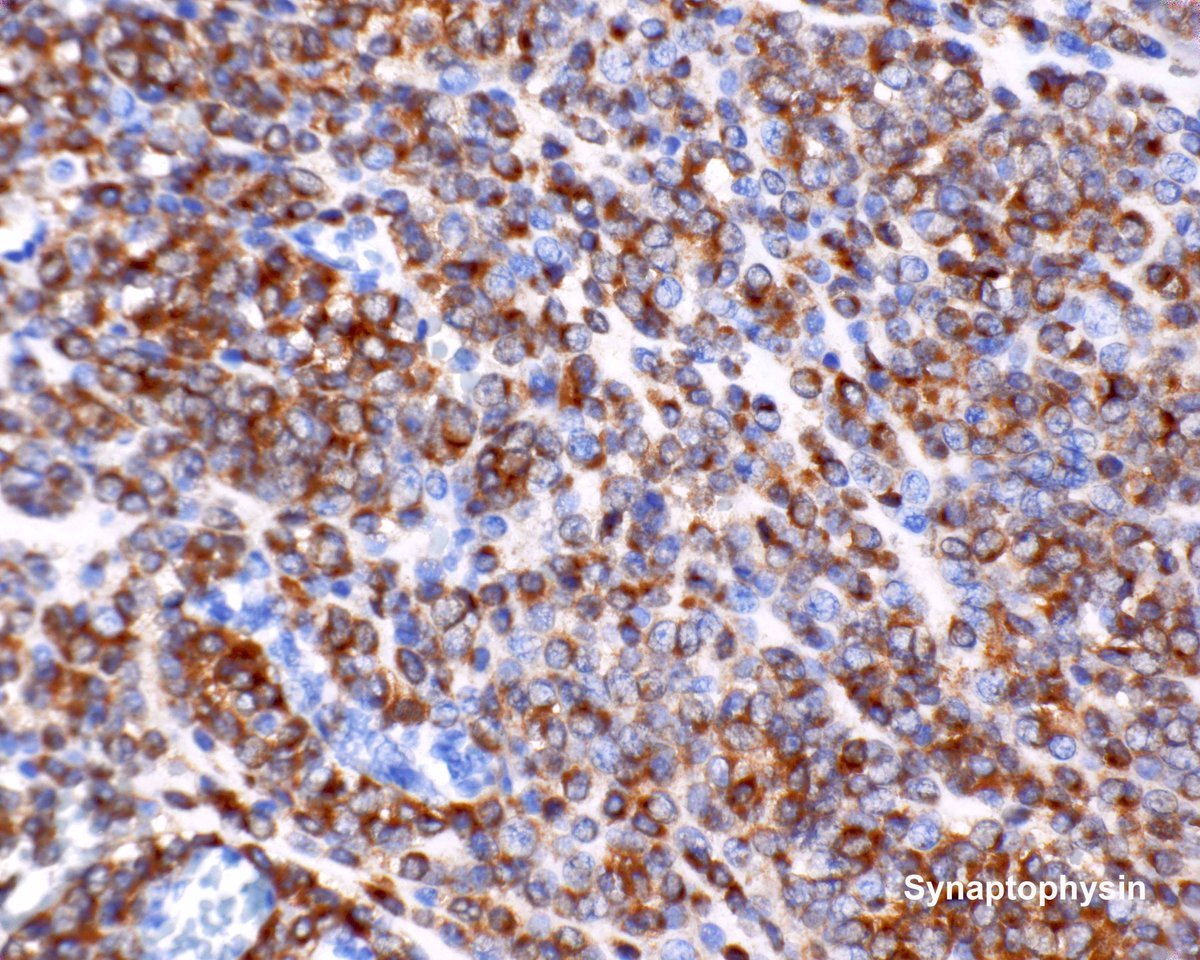
Gastric glomus tumor - don't be fooled by the synaptophysin.  They are negative for chromogranin and keratins.

Hatim_Almaghraby_CytoPathologist_Saudi
@saudicytopathol
A passionate pathologist and family man. Adj. Assistant Professor at KSU-HS T/RT educational only & not medical advise. @UoCampus @uhn @uoftmedicine @KSUHS
ID: 467696589
https://scholar.google.com/scholar?start=10&q=hatim+almaghraby&hl=iw&as_sdt=0,5 18-01-2012 19:06:11
5,5K Tweet
1,1K Followers
1,1K Following


Here is Editor-in-Chief Rhonda Yantiss discussing one of the best articles in Modern Pathology last year. Submit your articles and share your research! #PathX

Thank you to IAP-Hong Kong Div and HK Society of Cytopathology for hosting a successful 2 day #Cytopath course! Special thanks to course directors Syed Z. Ali and Gary Tse for inviting Yale Pathology speakers. Looking forward to future collaborations!!💥🔬#PathTwitter #pathology




TURKI ALALSHIKH بنوك الدم والمستشفيات في حاجه دائمه لمنتجات التبرع بالدم فعليها تقوم التدخلات الجراحية وعلاجات مرضى السرطان وأمراض الدم المبادرة جميلة ولفته للمرضى واصحاب الحاجه لمنتجات الدم. قد يعطي الإنسان من ماله ووقته وعلمه وخبرته ولكن أن يتبرع ببعض من جسده فهذا من قمم العطاء الإنساني




#IACtutorial in Singapore! Thrilled to have our #IACpresident Prof Syed Z. Ali leading the sessions. A global voice in #thyroid #cytopath #cytology